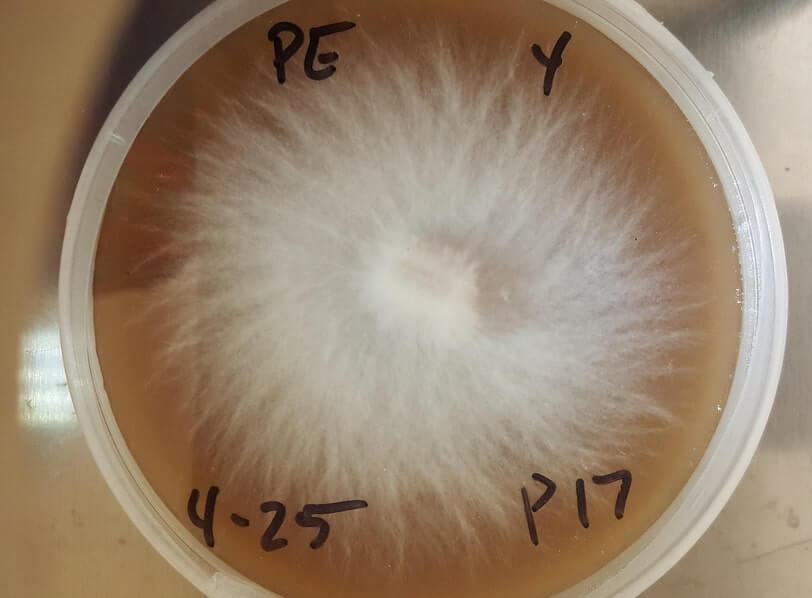
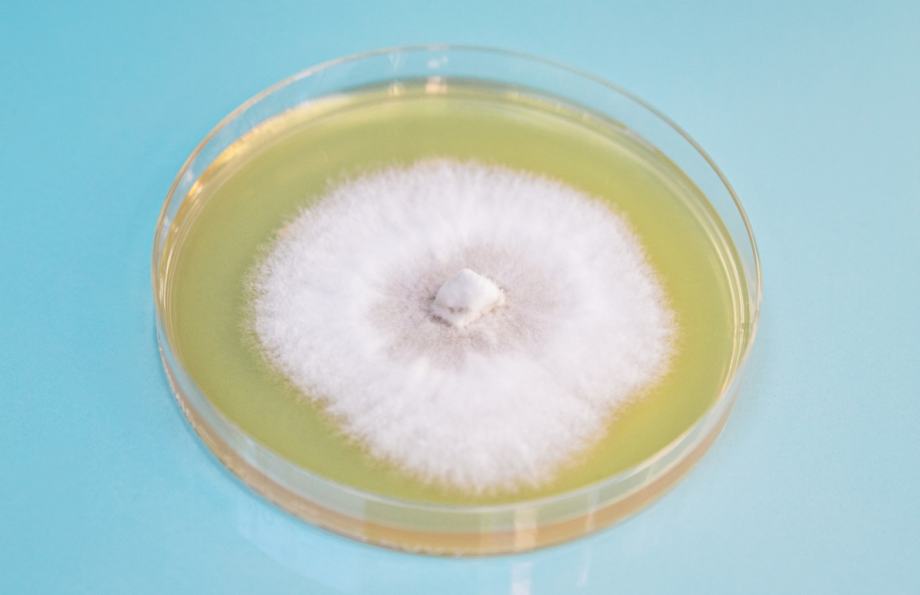

Ovaj oglas je neaktivan.
Pronjuškaj slične oglase.
Osnovne informacije
- Lokacija
- Vukovarsko-srijemska, Županja, Županja
- Vrsta
- ostalo
- Cijena se odnosi na
- komad
Opis oglasa
Predstavljamo našu hranjivu podlogu za uzgoj gljiva i mikrobiologiju. Paket sadrži 50g suhe materije što je dovoljno za 50-60 petrijevih posuda od 90mm.
Otkrijte puni potencijal vaših eksperimenata s gljivicama i istraživanja mikrobiologije s ovim izvanrednim proizvodom. Namijenjen profesionalcima i entuzijastima jednako, naš Agar prah za podlogu jamči optimalne uvjete rasta i izvanredne rezultate.
Kreiran s pažnjom, pruža čvrstu osnovu za uzgoj različitih vrsta gljiva i provođenje vrhunskih mikrobioloških istraživanja. Zaboravite na isprobavanje i pogreške, te prihvatite učinkovitost i dosljednost koje naš proizvod donosi vašim eksperimentima.
Ono što izdvaja našu hranjivu podlogu je iznimna nutritivna vrijednost. Obogaćen uravnoteženim mješavinom esencijalnih elemenata i minerala, pruža hranjive tvari koje vašim gljivama trebaju za napredak. Svjedočite brzom širenju micelija i obilnom plodonošenju dok vaše gljive napreduju u ovom optimalnom i hranjivom okruženju.
Naša hranjiva podloga ne samo da se ističe u performansama, već nudi i neusporedivu praktičnost. Pakiranje prilagođeno korisniku osigurava jednostavno čuvanje i rukovanje, omogućujući vam da se usredotočite na ono što je najvažnije - vaše eksperimente. Bez obzira jeste li iskusni istraživač ili strastveni ljubitelj, naš Agar prah za podlogu pojednostavljuje proces uzgoja, štedeći vam dragocjeno vrijeme i trud.
Podignite svoja znanstvena nastojanja i unaprijedite uzgoj gljiva s našim Agar prahom za podlogu. Doživite neusporedivu kvalitetu, pouzdanost i rezultate. Krenite danas i otključajte svijet mogućnosti.
Odaberite između:
MEA (agar s ekstraktom slada)
MEYA (agar s kvascem i ekstraktom slada)
Često postavljena pitanja:
Kako koristiti Agar prah za podlogu u uzgoju gljiva i mikrobiologiji?
Agar prah za podlogu koristite tako da ga otapate u odgovarajućoj količini vode ili otopine, prema uputama. Dobro promiješajte kako biste osigurali ravnomjerno raspršivanje. Zatim sterilizirajte podlogu i dodajte željene kulture gljiva ili mikroorganizama.
Koje su prednosti korištenja Agar praha za podlogu?
Agar prah za podlogu pruža čvrstu osnovu za rast gljiva i mikroorganizama, osiguravajući optimalne uvjete i dosljednost rezultata. Fino usitnjeni prah olakšava otapanje i ravnomjernu distribuciju, a nutritivna vrijednost potiče brzi rast i plodonošenje.
Koje su razlike između MEA (agar s ekstraktom slada) i MEYA (agar s kvascem i ekstraktom slada)?
MEA koristi ekstrakt slada kao izvor hranjivih tvari, dok MEYA dodatno sadrži i kvasac. Oba praha pružaju nutritivne elemente za rast gljiva, ali različiti sastojci mogu utjecati na specifične karakteristike rasta i preferencije određenih vrsta.
Koliko dugo traje sterilnost Agar praha za podlogu?
Agar prah za podlogu treba čuvati u zatvorenoj ambalaži kako bi se održala sterilnost. Provjerite rok trajanja na pakiranju i koristite prah prije isteka roka.
Kako pravilno skladištiti Agar prah za podlogu?
Preporučuje se čuvanje Agar praha za podlogu na hladnom i suhom mjestu, dalje od izravne sunčeve svjetlosti. Držite ga u zatvorenoj ambalaži kako biste očuvali sterilnost i spriječili vlagu ili kontaminaciju.
Otkrijte puni potencijal vaših eksperimenata s gljivicama i istraživanja mikrobiologije s ovim izvanrednim proizvodom. Namijenjen profesionalcima i entuzijastima jednako, naš Agar prah za podlogu jamči optimalne uvjete rasta i izvanredne rezultate.
Kreiran s pažnjom, pruža čvrstu osnovu za uzgoj različitih vrsta gljiva i provođenje vrhunskih mikrobioloških istraživanja. Zaboravite na isprobavanje i pogreške, te prihvatite učinkovitost i dosljednost koje naš proizvod donosi vašim eksperimentima.
Ono što izdvaja našu hranjivu podlogu je iznimna nutritivna vrijednost. Obogaćen uravnoteženim mješavinom esencijalnih elemenata i minerala, pruža hranjive tvari koje vašim gljivama trebaju za napredak. Svjedočite brzom širenju micelija i obilnom plodonošenju dok vaše gljive napreduju u ovom optimalnom i hranjivom okruženju.
Naša hranjiva podloga ne samo da se ističe u performansama, već nudi i neusporedivu praktičnost. Pakiranje prilagođeno korisniku osigurava jednostavno čuvanje i rukovanje, omogućujući vam da se usredotočite na ono što je najvažnije - vaše eksperimente. Bez obzira jeste li iskusni istraživač ili strastveni ljubitelj, naš Agar prah za podlogu pojednostavljuje proces uzgoja, štedeći vam dragocjeno vrijeme i trud.
Podignite svoja znanstvena nastojanja i unaprijedite uzgoj gljiva s našim Agar prahom za podlogu. Doživite neusporedivu kvalitetu, pouzdanost i rezultate. Krenite danas i otključajte svijet mogućnosti.
Odaberite između:
MEA (agar s ekstraktom slada)
MEYA (agar s kvascem i ekstraktom slada)
Često postavljena pitanja:
Kako koristiti Agar prah za podlogu u uzgoju gljiva i mikrobiologiji?
Agar prah za podlogu koristite tako da ga otapate u odgovarajućoj količini vode ili otopine, prema uputama. Dobro promiješajte kako biste osigurali ravnomjerno raspršivanje. Zatim sterilizirajte podlogu i dodajte željene kulture gljiva ili mikroorganizama.
Koje su prednosti korištenja Agar praha za podlogu?
Agar prah za podlogu pruža čvrstu osnovu za rast gljiva i mikroorganizama, osiguravajući optimalne uvjete i dosljednost rezultata. Fino usitnjeni prah olakšava otapanje i ravnomjernu distribuciju, a nutritivna vrijednost potiče brzi rast i plodonošenje.
Koje su razlike između MEA (agar s ekstraktom slada) i MEYA (agar s kvascem i ekstraktom slada)?
MEA koristi ekstrakt slada kao izvor hranjivih tvari, dok MEYA dodatno sadrži i kvasac. Oba praha pružaju nutritivne elemente za rast gljiva, ali različiti sastojci mogu utjecati na specifične karakteristike rasta i preferencije određenih vrsta.
Koliko dugo traje sterilnost Agar praha za podlogu?
Agar prah za podlogu treba čuvati u zatvorenoj ambalaži kako bi se održala sterilnost. Provjerite rok trajanja na pakiranju i koristite prah prije isteka roka.
Kako pravilno skladištiti Agar prah za podlogu?
Preporučuje se čuvanje Agar praha za podlogu na hladnom i suhom mjestu, dalje od izravne sunčeve svjetlosti. Držite ga u zatvorenoj ambalaži kako biste očuvali sterilnost i spriječili vlagu ili kontaminaciju.
Karta
Napomena: Prikazana je približna lokacija
- Oglas objavljen
- 08.04.2025. u 10:47
- Do isteka još
- oglas istekao
- Oglas prikazan
- 1654 puta